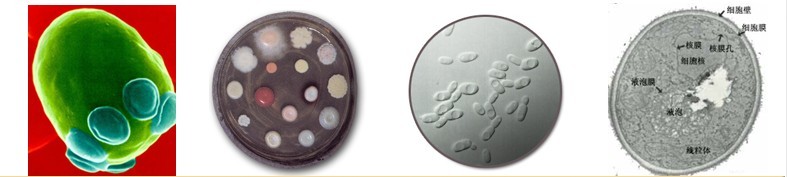

真核微生物是一大类具有真正细胞核,具有核膜与核仁分化的较高等的微生物,细胞内有线粒体等较复杂的细胞结构。这类微生物包括酵母菌、霉菌、微细藻类、原生动物和大型真菌等。
酵母菌是一类单细胞的真核微生物的通俗名称。其繁殖方式包括无性繁殖和有性繁殖。无性繁殖方式包括芽殖和裂殖。芽殖是酵母菌最普遍的繁殖方式。其过程是:成熟的母细胞在其形成芽体的部位长出芽细胞,芽细胞脱离母体,成为新的个体细胞。如果不脱离母细胞,又长出新芽,子细胞就和母细胞连接在一起,形成藕节状或竹节状的细胞串,称为假菌丝或真菌丝。少数酵母以裂殖方式进行繁殖,当母细胞长到一定大小时,细胞核开始分裂,之后,在细胞中间产生一隔膜,将细胞一分为二。还有些酵母菌可形成一些无性孢子如节孢子、掷孢子、厚垣孢子等。有性繁殖则是通过形成子囊和子囊孢子。




